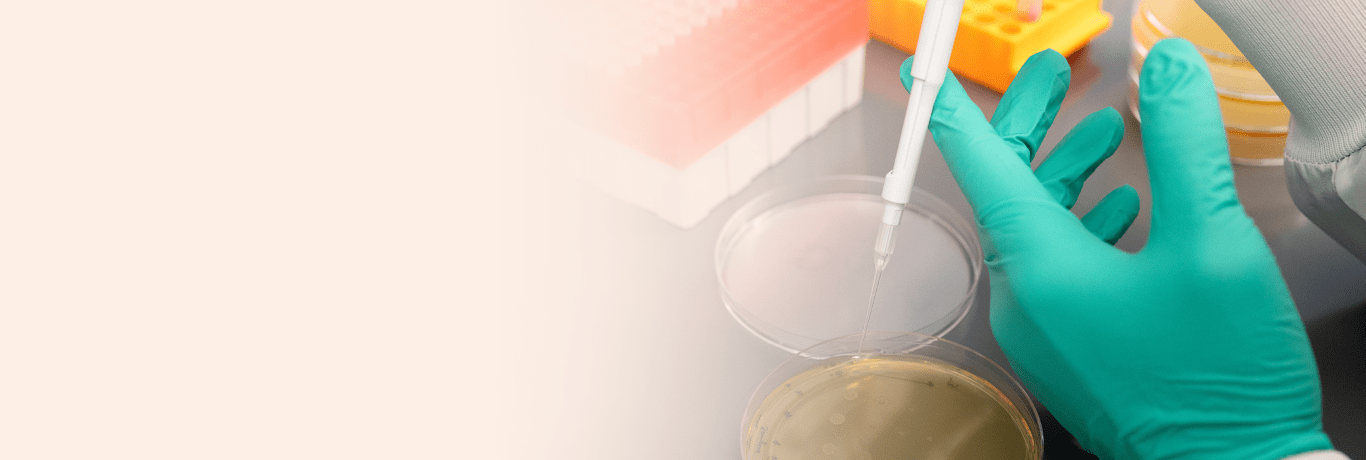
early-career-opportunities-banner

Recruitment for this study is on hold.
About Hepatitis B
Chronic hepatitis B (CHB) is a global public health issue. If left untreated, CHB can cause serious health problems, like scarring of the liver and liver damage. According to CDC (Centers for Disease Control and Prevention), an estimated 862,000 people in the U.S. are chronically infected with the hepatitis B virus. An infected mother can pass it to her baby at birth.
About Our Study
This study is evaluating the safety and efficacy of an investigational drug in children and adolescents (ages 2 to <18 years) with chronic hepatitis B virus infection.
If you think that your child or loved one would benefit from participating in this study, please email GS-US-320-1092@gilead.com.